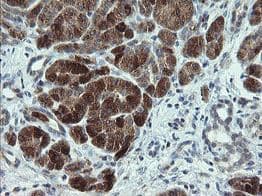
p15INK4b/CDKN2B Antibody (OTI3B6) - Azide and BSA Free

p15INK4b/CDKN2B Antibody (OTI3B6) - Azide and BSA Free
Novus Biologicals, part of Bio-Techne | Catalog # NBP2-73184

![Western Blot: p15INK4b/CDKN2B Antibody (OTI3B6)Azide and BSA Free [NBP2-73184] Western Blot: p15INK4b/CDKN2B Antibody (OTI3B6)Azide and BSA Free [NBP2-73184]](https://resources.bio-techne.com/images/products/p15INK4b-CDKN2B-Antibody-OTI3B6-Azide-and-BSA-Free-Western-Blot-NBP2-73184-img0001.jpg)
Conjugate
Catalog #
Key Product Details
Species Reactivity
Human, Mouse, Rat
Applications
Immunohistochemistry, Immunohistochemistry-Paraffin, Western Blot, Flow Cytometry, CyTOF-ready
Label
Unconjugated
Antibody Source
Monoclonal Mouse IgG1 Clone # OTI3B6
Format
Azide and BSA Free
Concentration
LYOPH mg/ml
Product Specifications
Immunogen
Full length human recombinant protein of human CDKN2B(NP_004927) produced in HEK293T cell.
Reactivity Notes
Please note that this antibody is reactive to Mouse and derived from the same host, Mouse. Mouse-On-Mouse blocking reagent may be needed for IHC and ICC experiments to reduce high background signal. You can find these reagents under catalog numbers PK-2200-NB and MP-2400-NB. Please contact Technical Support if you have any questions.
Clonality
Monoclonal
Host
Mouse
Isotype
IgG1
Theoretical MW
14.5 kDa.
Disclaimer note: The observed molecular weight of the protein may vary from the listed predicted molecular weight due to post translational modifications, post translation cleavages, relative charges, and other experimental factors.
Disclaimer note: The observed molecular weight of the protein may vary from the listed predicted molecular weight due to post translational modifications, post translation cleavages, relative charges, and other experimental factors.
Scientific Data Images for p15INK4b/CDKN2B Antibody (OTI3B6) - Azide and BSA Free
Western Blot: p15INK4b/CDKN2B Antibody (OTI3B6)Azide and BSA Free [NBP2-73184]
Western Blot: p15INK4b/CDKN2B Antibody (OTI3B6) - Azide and BSA Free [NBP2-73184] - Analysis of HEK293T cells were transfected with the pCMV6-ENTRY control (Left lane) or pCMV6-ENTRY CDKN2B.Flow Cytometry: p15INK4b/CDKN2B Antibody (OTI3B6) - Azide and BSA Free [NBP2-73184]
Flow Cytometry: p15INK4b/CDKN2B Antibody (OTI3B6) - Azide and BSA Free [NBP2-73184] - Analysis of HEK293T cells transfected with either overexpress plasmid(Red) or empty vector control plasmid(Blue) were immunostaining by CDKN2B antibody.Immunohistochemistry-Paraffin- p15INK4b/CDKN2B Antibody (OTI3B6) -
Immunohistochemistry-Paraffin- p15INK4b/CDKN2B Antibody (OTI3B6) - Human pancreas tissue within the normal limits using anti-CDKN2B mouse monoclonal antibody. (Heat-induced epitope retrieval by 10mM citric buffer, pH6.0100 C for 10min.Applications for p15INK4b/CDKN2B Antibody (OTI3B6) - Azide and BSA Free
Application
Recommended Usage
Flow Cytometry
1:100
Immunohistochemistry
1:150
Immunohistochemistry-Paraffin
1:150
Western Blot
1:2000
Formulation, Preparation, and Storage
Purification
Immunogen affinity purified
Reconstitution
we recommend adding 100uL distilled water to a final antibody concentration of about 1 mg/mL. To use this carrier-free antibody for conjugation experiment, we strongly recommend performing another round of desalting process.
Formulation
Lyophilized from PBS (pH 7.3) with 8% Trehalose
Format
Azide and BSA Free
Preservative
No Preservative
Concentration
LYOPH mg/ml
Shipping
The product is shipped with polar packs. Upon receipt, store it immediately at the temperature recommended below.
Stability & Storage
Store at -20C. Avoid freeze-thaw cycles.
Background: p15INK4b/CDKN2B
Long Name
p15 Cyclin Dependent Kinase 4 Inhibitor 2B
Alternate Names
CDKN2B, MTS2
Gene Symbol
CDKN2B
Additional p15INK4b/CDKN2B Products
Product Documents for p15INK4b/CDKN2B Antibody (OTI3B6) - Azide and BSA Free
Product Specific Notices for p15INK4b/CDKN2B Antibody (OTI3B6) - Azide and BSA Free
This product is for research use only and is not approved for use in humans or in clinical diagnosis. Primary Antibodies are guaranteed for 1 year from date of receipt.
Loading...
Loading...
Loading...
Loading...
Loading...
Loading...
![Flow Cytometry: p15INK4b/CDKN2B Antibody (OTI3B6) - Azide and BSA Free [NBP2-73184] Flow Cytometry: p15INK4b/CDKN2B Antibody (OTI3B6) - Azide and BSA Free [NBP2-73184]](https://resources.bio-techne.com/images/products/p15INK4b-CDKN2B-Antibody-OTI3B6-Azide-and-BSA-Free-Flow-Cytometry-NBP2-73184-img0002.jpg)